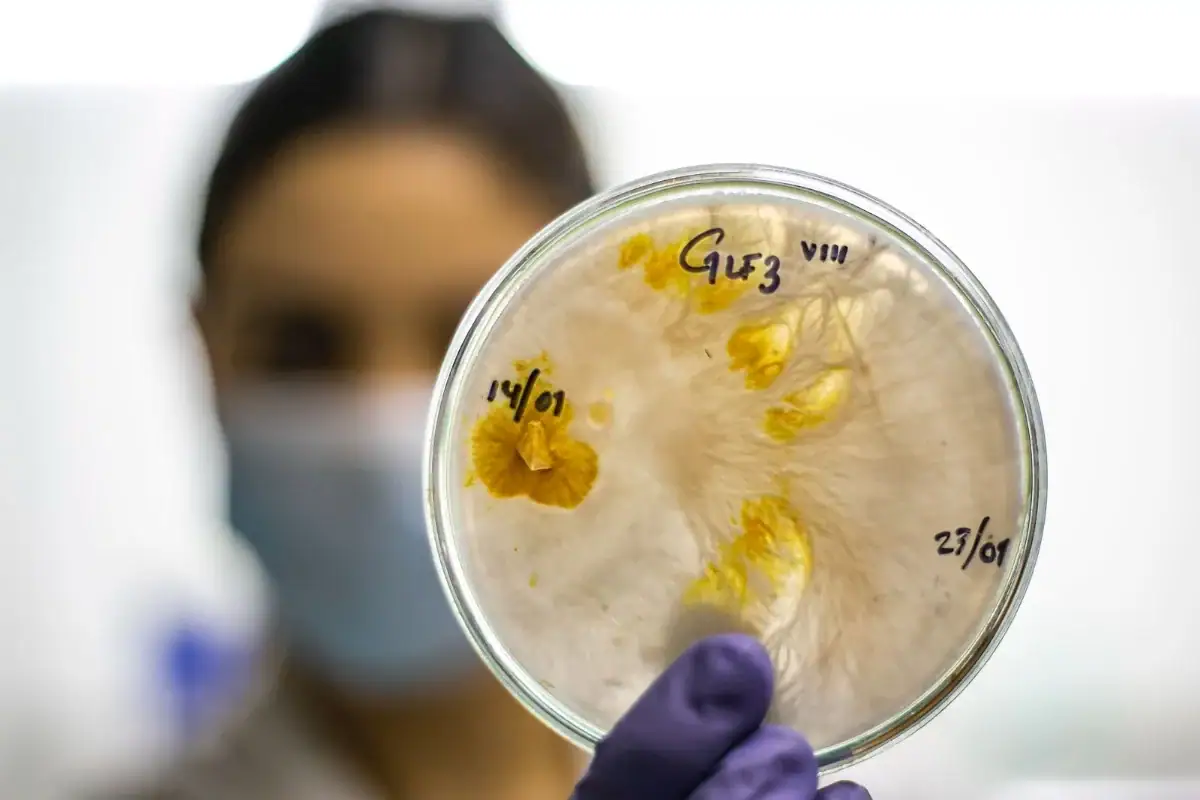
Jalisco, segundo lugar nacional en solicitud de patentes durante 2025

Jalisco, segundo lugar nacional en solicitud de patentes durante 2025
Con 230 solicitudes de patentes, en 2025, Jalisco se ubicó en el segundo lugar nacional de acuerdo con información del Instituto Mexicano de la Propiedad Industrial (IMPI).
La entidad aportó 20 por ciento de las mil 150 solicitudes de patentes de mexicanos. Las solicitudes de patentes nacionales y extranjeras sumaron en total 15 mil 845.
“En 2025, Jalisco se mantuvo en una producción de solicitudes de patente equivalente al 20 por ciento de la aportación del total del País”, señaló Fanny Guadalupe Valdivia Márquez, secretaria de Innovación, Ciencia y Tecnología (SICyT).
“Somos el segundo lugar a nivel nacional, y esto, de manera ininterrumpida, durante diez años, nos hemos posicionado en los primeros lugares”.
México decrece en número de solicitudes de patentes 2025
En contraste, México decreció 2.1 por ciento en solicitudes de patentes nacionales y extranjeras, y 1.8 por ciento en solicitudes de patentes solo de mexicanos.
La Ciudad de México registró 240 solicitudes, el Estado de México se colocó en la tercera posición con 83 peticiones; seguido de Nuevo León y Puebla con 70 peticiones, respectivamente.
La titular de la SICyT aseguró que se implementó una política pública sólida para apoyar la protección de la propiedad intelectual en el estado; en 2025, se apoyaron 265 proyectos tecnológicos para su protección, de los cuales 57.3 por ciento son patentes.
Las áreas técnicas de las patentes son mecánica, diseño, electrónica, biotecnología, química, eléctrica y software. Las áreas de sectores de impacto son: salud, mueblero, dispositivos, agropecuario y ambiental.
SICyT también realizó 232 asesorías y ha capacitado a mil 527 personas en Propiedad Intelectual y Transferencia Tecnológica, informaron las autoridades.
Jalisco avanza en entrega de Tarjeta Única; hay más de 800 mil registros

La coordinadora general de Desarrollo Social del Gobierno de Jalisco, Andrea Blanco Calderón, informó que hasta el momento se reportan 835 mil registros para la Tarjeta Única“Al Estilo Jalisco”.
Anunció que se espera un nuevo corte de entrega al regresar de la Semana Santa. A la fecha se han entregado 320 mil plásticos, de acuerdo con las autoridades.
Ante los medios de comunicación, Blanco Calderón detalló que la meta estatal es alcanzar los dos millones de tarjetas a lo largo del año, cifra que se espera superar antes de diciembre, ya que la tarjeta se convertirá en el medio principal para dispersar los programas sociales del gobierno.
“La meta es llegar a los dos millones de personas. Esto es bien importante. No es obligatorio afiliarse, pero vamos a dispersar los programas sociales a través de la tarjeta única”, explicó la funcionaria.
Aunque ya no es requisito para el descuento en transporte público, sí será obligatoria para recibir los apoyos de la Secretaría de Asistencia Social y otros programas estatales.
Todos los apoyos de la Secretaría de Asistencia Social se dispersarán exclusivamente a través de la Tarjeta Única aunque señaló que los padrones como el de cuidadoras, personas con discapacidad son independientes, es decir las personas pueden inscribirse sin tener la tarjeta, pero para recibir el primer pago bimestral sí se requerirá contar con ella.
Instalarán módulos para tramitar la Tarjeta Única de Jalisco
Para facilitar el proceso, el gobierno instalará módulos especiales tanto en la Zona Metropolitana de Guadalajara como en el interior del estado, dirigidos especialmente a personas con discapacidad, cuidadoras y otros grupos vulnerables.
Blanco Calderón resaltó que los primeros pagos de los nuevos apoyos comenzarán en el mes de mayo. Se trata de pagos bimestrales y el primer desembolso cubrirá los meses de abril y mayo de manera retroactiva.
Los meses de enero, febrero y marzo no serán cubiertos porque los padrones son “cero” y las reglas de operación apenas fueron publicadas y validadas.
La coordinadora general de Desarrollo Social aseguró que hay tarjetas suficientes para todas las personas que las soliciten y que los módulos de afiliación seguirán operando con normalidad.
Jalisco arranca campaña 2026 de vacunación antirrábica

El Gobierno de Jalisco presentó este lunes (06.04.26) la campaña de vacunación antirrábica y esterilización canina y felina 2026 en el Parque Canino Altamira.
Durante la presentación, la coordinadora general de Desarrollo Social, Andrea Blanco Calderón, destacó el éxito que ha tenido Jalisco en el control de la rabia canina.
“El año pasado, en enero de este año, se cumplieron 31 años de no tener ningún caso de rabia transmitida por perros en nuestra entidad. 31 años. Esto es gracias al esfuerzo de las autoridades, pero también de todas las personas que tienen algún perrito o algún gatito en casa y esa corresponsabilidad”, señaló la coordinadora.
Blanco Calderón explicó que en 2025 se aplicaron 591 mil 700 dosis de vacuna antirrábica y anunció la meta para este 2026.
“¿Y qué queremos este año 2026? […] llegar al millón de vacunas aplicadas, antirrábicas para perros y para gatos. Recordar que es totalmente gratuita la aplicación de esta vacuna”.

La funcionaria hizo un llamado a promover la vacunación antirrábica y los servicios de esterilización canina y felina gratuitos, tanto en puestos fijos como en brigadas móviles.
“El año pasado, a mediados de año, compramos dos de estos quirófanos móviles con una inversión de cuatro millones de pesos para poder reforzar la esterilización totalmente gratuita, no únicamente en zona metropolitana, sino en el interior del estado”, detalló.
Blanco Calderón resaltó que con estas brigadas “Yo Jalisco” se ha logrado llegar a más de 75 municipios del estado.
-
ZMG31 marzo 2026Invierten casi 190 mdp en vialidad Chulavista–El Cuervo en Tlajomulco
-
Jalisco1 abril 2026Jalisco busca que 60% de su energía sea renovable en 2030
-
Jalisco6 abril 2026Jalisco avanza en entrega de Tarjeta Única; hay más de 800 mil registros
-
Jalisco31 marzo 2026MiBici amplía a 45 minutos los viajes en Semana Santa












